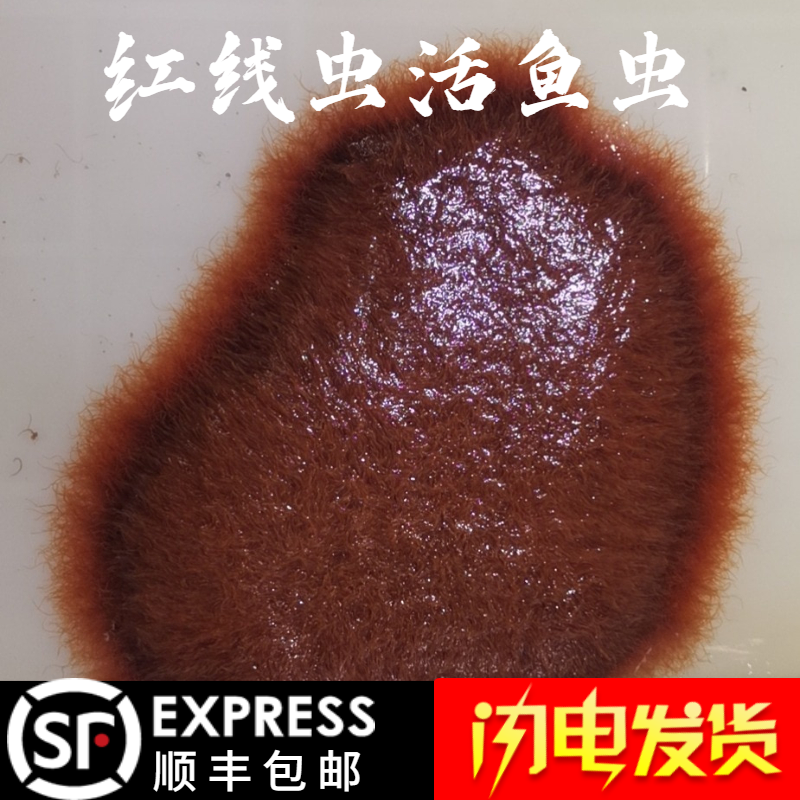
06 25月销56件红线虫活体水蚯蚓热带开口丝虫饵料22.

口丝虫

鱼口丝虫病
图片尺寸800x600
该方法对健康观赏鱼预防口丝虫病也很适用.
图片尺寸688x703
口丝虫鱼波豆虫白云病
图片尺寸600x450
鱼口丝虫
图片尺寸800x600
丝虫病
图片尺寸304x220
狗狗患有"寄生虫"的几大症状,赶紧驱虫吧!
图片尺寸640x470
小瓜虫的常用杀灭方法越来越没有效果病害高发期如何有效防治
图片尺寸800x946
颚口线虫成虫
图片尺寸449x582
丝虫病会导致全身的过敏反应发病过程分为四个时期和三种类型
图片尺寸482x511
颚口线虫
图片尺寸268x187
鱼口丝虫病
图片尺寸650x500
鱼口丝虫病
图片尺寸500x350
06 25月销56件红线虫活体水蚯蚓热带开口丝虫饵料22.
图片尺寸800x800
2.口丝虫3.车轮虫4.鱼鲺5.中华鳋6.斜管虫7.球虫病8.小瓜虫9.
图片尺寸640x507
请问鱼患了中华六鞭毛虫,口丝虫用什么药好呢?
图片尺寸3120x4160
十八,口丝虫病(鱼波豆虫病,白云病):常在硬物上刮擦,抖动,体表发炎,立
图片尺寸490x308
观赏鱼翻鳃是怎么回事主要源于三个问题需要进行手术吗
图片尺寸1222x890
例如口丝虫病,小瓜虫病,车轮虫病,斜管虫病等.
图片尺寸600x332
莱口丝虫冷冻睡眠面膜深层补水滋养果冻面膜舒缓肌肤修复凝胶20支/盒
图片尺寸790x880
鱼口丝虫病
图片尺寸800x600